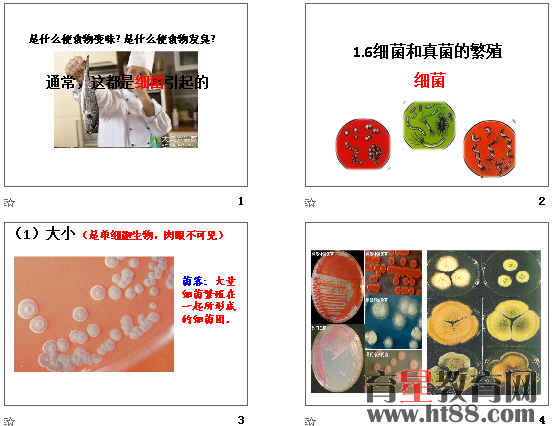
查看预览图

《细菌和真菌的繁殖》ppt1
- 手机网页: 浏览手机版
- 资源类别: 浙教版 / 综合资源 / 初中科学
- 文件类型: ppt
- 资源大小: 15.85 MB
- 资源评级:

- 更新时间: 2016/2/21 19:41:57
- 资源来源: 会员转发
- 下载情况: 本月:0 总计:0
- 下载点数: 1 下载点 如何增加下载点
传统下载

- 资源简介:
共44张,图文结合,内容详实。
传统下载
搜索更多相关资源
- 说明:“点此下载”为无刷新无重复下载提示方式,下载文件会自动命名;“传统下载”为打开新页面进行下载,有重复下载提示。如果使用“点此下载”有困难,请使用“传统下载”。
- 提示:非零点资源点击后将会扣点,不确认下载请勿点击。
- 我要评价有奖报错加入收藏下载帮助
下载说明:
- 没有确认下载前请不要点击“点此下载”、“传统下载”,点击后将会启动下载程序并扣除相应点数。
- 如果资源不能正常使用或下载请点击有奖报错,报错证实将补点并奖励!
- 为确保所下资源能正常使用,请使用[WinRAR v3.8]或以上版本解压本站资源。
- 站内部分资源并非原创,若无意中侵犯到您的权利,敬请来信联系我们。